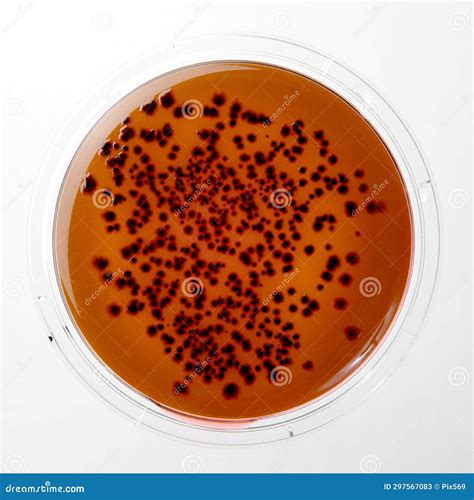
Placa de Petri mostrando colonias de Salmonella spp. en Agar Verde Brillante

Introducción a los Medios de Cultivo
Un medio de cultivo es el conjunto de nutrientes, factores de crecimiento y otros componentes que crean las condiciones nutricionales necesarias para el crecimiento de microorganismos.
Los medios de cultivo pueden clasificarse por su estado físico:
- Líquidos (Caldos): No contienen ningún agente gelificante, por lo que los microorganismos crecen por todo el medio. El crecimiento en este tipo de medios es más rápido puesto que la movilidad permite acceder de una forma más fácil a los nutrientes.
- Sólidos: Tienen una proporción de agar de, aproximadamente, el 1,5%. El crecimiento se desarrolla en la superficie del medio.
- Semisólidos: Son aquellos que contienen una proporción de agar inferior al 0,5%.
También se clasifican por su propósito o composición:
- Medios simples.
- Medios enriquecidos: Son medios simples o comunes, a los que se le añaden ciertos elementos como sangre, suero, líquido ascítico, huevo, glucosa, vitaminas, etc.
- Medios selectivos: Diseñados para inhibir el crecimiento de ciertos microorganismos y favorecer el de otros.
- Medios diferenciales: Permiten distinguir entre diferentes tipos de microorganismos basándose en sus propiedades metabólicas.
- Medios de enriquecimiento.
Para la preparación de medios de cultivo, se siguen las instrucciones del fabricante. A modo general, consiste en reconstituirlos, es decir, disolverlos en agua destilada según la concentración deseada. Si se desea un medio sólido, es necesario disolver el agar en el medio líquido, lo que a menudo requiere agitación y calentamiento. Independientemente del estado físico deseado, el medio de cultivo reconstituido debe esterilizarse para evitar el crecimiento de cualquier microorganismo contaminante.

Caldo EC: Medio Selectivo para Escherichia coli y Coliformes
Definición y Aplicación
El caldo EC, o caldo Escherichia coli, es un medio de cultivo líquido selectivo. Este medio es recomendado por la Standard Methods para el recuento de coliformes totales y fecales, mediante la técnica del número más probable (NMP) en muestras de agua y alimentos, donde el principal agente involucrado es la Escherichia coli.
El estudio microbiológico de agua y alimentos por el número más probable (NMP) para la búsqueda de coliformes totales y fecales es un protocolo conformado por varias fases: fase presuntiva, fase confirmatoria y fase de completación.
Composición y Función de sus Componentes
El caldo EC está compuesto por tripteína, lactosa, sales biliares, fosfato dipotásico, fosfato monopotásico, cloruro de sodio y agua.
- La tripteína proporciona los elementos nutricionales, siendo una excelente fuente de péptidos y aminoácidos.
- El fosfato dipotásico y el fosfato monopotásico actúan como un sistema equilibrador del pH (soluciones tampón o buffer), ayudando a mantener el pH del medio de cultivo dentro de un rango adecuado para el crecimiento de los microorganismos.
Serotipos y Variantes
Cabe destacar que existen muchos serotipos de Escherichia coli. Este medio tiene la capacidad de permitir el desarrollo de todas ellas, pero sin poder diferenciarlas entre sí.
Okrend y Rose crearon una variedad del caldo EC, denominado caldo EC modificado con novobiocina.
Preparación del Caldo EC
Para la preparación del caldo EC:
- Pesar 37,4 gr del medio deshidratado.
- Disolver en 1 litro de agua destilada.
- La mezcla se debe dejar reposar por 5 minutos.
- Una vez disuelto, se distribuye en tubos de ensayo previamente acondicionados con un tubo Durham dentro.
- El pH del medio debe quedar en 6,9 ± 0,2.
- Los caldos se guardan en nevera hasta su uso.

Interpretación y Control de Calidad
La interpretación de los resultados del caldo EC es la siguiente: los tubos turbios con producción de gas se consideran positivos.
Los caldos EC positivos pasan a la fase completa confirmatoria, la cual consiste en resembrar en medios selectivos como agar Mac Conkey, agar EMB o agar Endo.
Control de Calidad del Caldo EC
De cada lote de medio preparado se debe hacer un control de calidad. En primer lugar, se debe evaluar la esterilidad del medio. En este sentido, se incuban uno o dos caldos sin inocular en aerobiosis por 24 horas a 37 °C.
En el control de desarrollo, se espera un desarrollo microbiano satisfactorio, observando un caldo turbio con producción de gas para E. coli. Otras cepas que pueden ser incluidas en el control son: Staphylococcus aureus ATCC 25923 y Enterococcus faecalis ATCC 29212.
Tip 1 Christian Saldaña: Control de Calidad en Medios de Cultivo
Verde Brillante: Agente Inhibidor y Medio Selectivo
El Componente Verde Brillante
El verde brillante es una sustancia inhibidora que impide el crecimiento de todas las bacterias gram positivas y de la mayoría de gram negativas.
Agar Verde Brillante
El Agar Verde Brillante es un medio de enriquecimiento altamente selectivo para el aislamiento de Salmonella spp., excepto S. typhi y S. paratyphi, a partir de muestras clínicas, alimentos y otros materiales de importancia sanitaria.
Para la preparación de este medio, que incluye la adición de la sustancia inhibidora, se requiere agitar durante 2 o 3 minutos y autoclavar a 118-121°C durante 15 minutos.
Medios Confirmatorios Complementarios
Para la confirmación de los resultados obtenidos, por ejemplo, con el caldo EC, se utilizan medios selectivos y diferenciales como el Agar MacConkey y el Agar Eosina Azul de Metileno (EMB).
Agar MacConkey
El Agar MacConkey es un medio diferencial y selectivo muy utilizado para el aislamiento e identificación de enterobacterias (bacilos gramnegativos). Lleva en su composición sales biliares y cristal violeta que inhiben el crecimiento de grampositivos y hongos. Las bacterias fermentadoras de lactosa (lactosa+) acidifican el medio y adquieren un color rosado (por ejemplo, E. coli).
Agar Eosina Azul de Metileno (EMB)
El Agar EMB es similar al MacConkey, pero contiene eosina y azul de metileno como indicadores. Se utiliza para el aislamiento y diferenciación de enterobacterias fermentadoras y no fermentadoras de lactosa. El crecimiento de E. coli en este medio es característico.